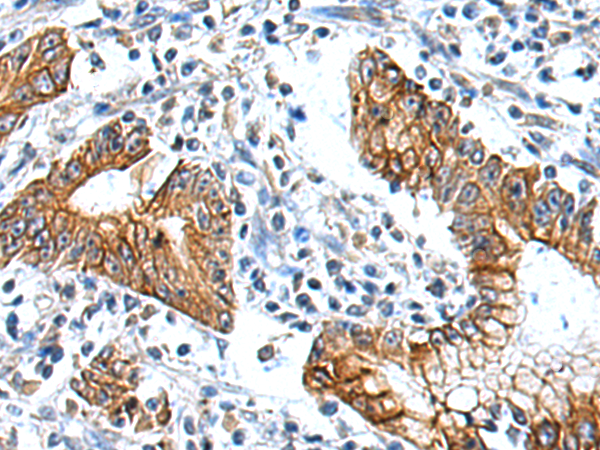

-
分类: 科研抗体货号: P12556别名: CYCT2应用: WB,IHC反应种属: Human
-
分类: 科研抗体货号: P12570别名: HOX4; HOX4E; HOX5.4应用: IHC反应种属: Human, Mouse
-
分类: 科研抗体货号: P12589别名: ODC; ODC1应用: IHC反应种属: Human
-
分类: 科研抗体货号: P12569别名: mGlu5; GPRC1E; MGLUR5; PPP1R86应用: IHC反应种属: Human, Mouse, Rat
-
分类: 科研抗体货号: P12609别名: MRMV4; NTN1L应用: IHC反应种属: Human, Mouse, Rat
-
分类: 科研抗体货号: P12588别名: A2MD; CPAMD5; FWP007; S863-7应用: IHC反应种属: Human
-
分类: 科研抗体货号: P12568别名: GLUR2; mGlu2; GPRC1B; MGLUR2应用: IHC反应种属: Human, Mouse, Rat
-
分类: 科研抗体货号: P12608别名: NOS1; NOS-1; SPGF12; EC_Rep1a; ZC2HC12A应用: WB反应种属: Human, Mouse
-
分类: 科研抗体货号: P12586别名: PW1; ZNF904; ZSCAN24; ZKSCAN22应用: IHC反应种属: Human
-
分类: 科研抗体货号: P12567别名: KRML; MCTO应用: IHC反应种属: Human, Mouse, Rat

鄂公网安备42018502007531号
鄂公网安备42018502007531号

